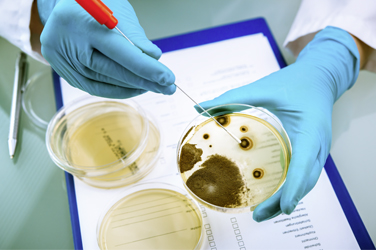
Análisis en laboratorio.

Análisis
Tiempo de lectura: 2 min.
Publicado el 08 enero 2025
Novartis se muestra más optimista de cara al futuro
Tras desprenderse de numerosas actividades en los últimos años, la farmacéutica suiza se concentra en sus productos innovadores patentados. Vea nuestro análisis sobre el valor.





